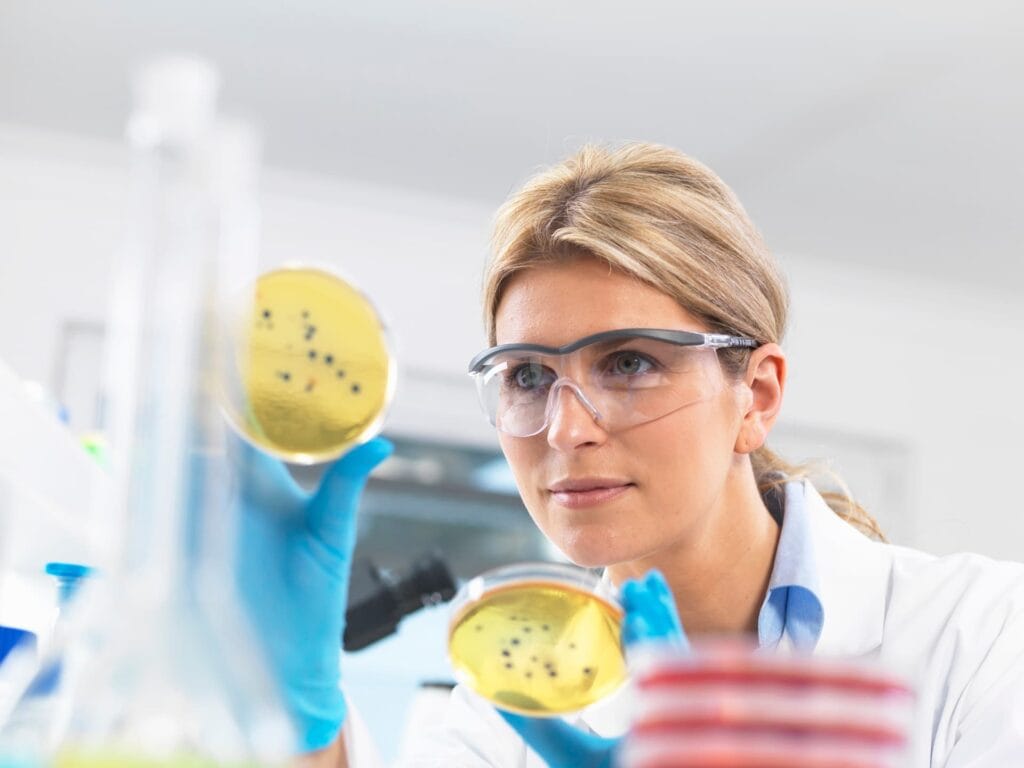
oral health

Validated by OwlCore’s 6-Phase Scientific Protocol, Moringa Magic integrates bioactive phytocompounds, adaptogenic stress regulators, trace mineral synergy, and ancestral botanical wisdom—to promote hormonal balance, digestive harmony, and mitochondrial biogenesis, aligned with modern standards of immune and metabolic health.

Your body may be trying to tell you something. These aren’t just occasional discomforts — they’re signs of disrupted metabolism and overwhelmed mitochondria. From chronic stress to nutrient depletion, modern life quietly erodes cellular function. True wellness begins by restoring balance at the source — supporting hormonal flow, detox pathways, and mitochondrial biogenesis from within.
Moringa Magic was developed through OwlCore’s 6-phase scientific validation system — combining adaptogenic phytochemistry, mineral synergy, metabolic insight, and real user feedback — to deliver a botanical supplement that works in sync with your body. From blood sugar control and cortisol modulation to digestive relief and cellular energy, this formula empowers functional health, grounded in rigorous scientific evidence.
Disclaimer: This content is not medical advice. For chronic health conditions, consult a qualified healthcare practitioner.
Individuals struggling with blood sugar spikes, chronic fatigue, or stress-related hormone imbalance
People looking to support their immune system naturally using botanical, nutrient-dense supplements
Adults experiencing digestive issues, bloating, or slow metabolism who seek home remedies for swollen stomach and improved gut health
Those wanting stimulant-free, clinically-backed support for cortisol regulation and mitochondrial biogenesis
Individuals dealing with mood swings, nutrient depletion, or inflammation linked to modern stress and poor dietary patterns
Moringa Magic is an OwlCore-approved botanical formula designed to help restore metabolic balance, enhance cellular energy, and support hormonal resilience — all without synthetic stimulants or artificial additives. Its formulation blends science-validated polyphenols, mineral cofactors, and adaptogenic plant compounds to promote full-spectrum wellness from within.
Restores balance to the oral microbiome and supports gum and teeth resilience
Reduces tooth sensitivity and strengthens enamel over time
Supports natural oral hygiene routines without disrupting saliva or pH balance
Freshens breath and reduces bacterial biofilm naturally
Helps maintain microbial integrity for long-term dental health
Combines probiotic and herbal mouth care in a stimulant-free, science-validated formulation
With a plant-powered, stimulant-free formula, Moringa Magic aims to be the most trusted natural metabolic support — offering multi-level benefits for hormonal balance, energy, and long-term cellular health.
“Unlike most energy or hormone-balancing supplements that rely on synthetic isolates, Moringa Magic is built on adaptogenic science, peer-reviewed metabolic research, and bioavailable plant-based compounds. This is what natural wellness support should look like.”
All ingredients traceable to source — including probiotic strains and herbal mouth care components
Manufactured in FDA-compliant, GMP-certified environments
Peer-reviewed references for every botanical extract and probiotic used
Tested for CFU viability, purity, and microbial integrity across all batches
Feedback tracked from real users with issues like tooth sensitivity, bleeding gums, or enamel wear
Positioned as one of the most trusted natural oral care products for healthy teeth and gums
Helps restore a balanced oral microbiome for long-term dental health
Reduces gum inflammation and supports healthy gum tissue
Freshens breath naturally without synthetic additives
Aids in tooth sensitivity treatment and enamel defense
Supports oral hygiene routines with daily-use convenience
Complements essential dental care for total gum and teeth support

Chronic stress and elevated cortisol levels impair metabolic balance and damage mitochondria. Moringa’s adaptogenic properties modulate cortisol release, while flavonoids such as quercetin and kaempferol inhibit NF‑κB-mediated cytokines like TNF‑α and IL‑1β, helping to reduce inflammation and support hormonal homeostasis (HealthPrimitive).
Key Takeaways:
Moringa acts as a natural adaptogen, helping to lower cortisol under stress
Flavonoids inhibit inflammatory enzymes and cytokine pathways
These actions support hormone regulation and reduce insulin resistance
Final Note:
This adaptogenic matrix supports endocrine resilience and immune modulation, helping balance cortisol, reduce inflammatory cascades, and promote long-term hormonal health — without synthetic hormonal regulators.

Moringa’s nutrient-dense profile stimulates mitochondrial renewal via AMPK-PGC‑1α activation. Its chlorogenic acid, phenolic antioxidants, and minerals boost oxidative capacity and ATP output. Studies show improved energy metabolism and biogenesis in multiple models (PMC).
Key Takeaways:
Moringa compounds activate cellular pathways for mitochondrial growth
Antioxidants reduce oxidative mitochondrial damage and stabilize function
Nutrient synergy promotes long-term metabolic energy and resilience
Final Note:
This phytonutrient formula enhances mitochondrial biogenesis naturally, supporting better energy production, reduced fatigue, and foundational vitality — without caffeine, stimulants or synthetic energizers.

Moringa leaves naturally provide iron, zinc, magnesium, vitamin C and B-complex nutrients — all essential for adrenal, thyroid, and reproductive hormone synthesis. Studies show these nutrients support enzyme activation, cortisol regulation, and neurotransmitter balance for full hormonal support (medicalnewstoday.com).
Key Takeaways:
Nutrient deficiencies can disrupt hormonal feedback loops and elevate stress response.
Moringa restores key vitamins and minerals needed for cortisol and thyroid balance.
These nutrients support energy metabolism and hormonal stability without stimulants.
Final Note:
By addressing hidden nutrient gaps through a botanical source, Moringa Magic promotes hormonal resilience and adrenal recovery — helping the body respond calmly to daily stressors.

Isothiocyanates, quercetin, and kaempferol in moringa are powerful antioxidants that reduce reactive oxygen species and support cellular repair. These polyphenols protect mitochondrial membranes and prevent inflammatory damage to metabolic tissues (ncbi.nlm.nih.gov).
Key Takeaways:
Oxidative stress damages mitochondria and accelerates tissue aging.
Moringa polyphenols neutralize free radicals and reduce inflammatory signals.
Long-term use supports cellular defense, detox, and energy recovery.
Final Note:
By protecting mitochondrial and hormonal tissues from oxidative overload, Moringa Magic supports sustained metabolic function and long-term cellular integrity.

Moringa contains quercetin, chlorogenic acid and B-complex vitamins that stimulate cellular energy pathways and support mitochondrial biogenesis (ncbi.nlm.nih.gov). These compounds regulate oxidative stress, modulate AMPK activation, and promote hormonal stability through enhanced ATP production.
Key Takeaways:
Impaired mitochondrial function can affect energy, metabolism, and hormone response.
Moringa bioactives stimulate mitochondrial biogenesis and protect against oxidative damage.
B-complex vitamins enhance energy conversion for adrenal and endocrine resilience.
Final Note:
By nourishing your cells with natural mitochondrial cofactors, Moringa Magic enhances hormonal energy balance — promoting vitality without caffeine or synthetic stimulants.

Moringa’s isothiocyanates, saponins, and polyphenols have demonstrated anti-inflammatory effects on gut lining and systemic cytokine signaling. These compounds may influence the gut–brain axis, reduce cortisol, and help balance immune reactivity.
Key Takeaways:
Chronic inflammation disrupts hormonal signaling and immune homeostasis.
Moringa’s phytonutrients reduce pro-inflammatory cytokines and improve gut barrier integrity.
This synergy supports balanced cortisol, immune defense, and mood resilience.
Final Note:
Moringa Magic provides a botanical path to hormonal calm — supporting immunity, stress modulation, and digestive resilience in one adaptogenic formula.

Cultural Narrative – Known as the “Miracle Tree” across Africa and Asia, Moringa oleifera has been revered for centuries in Ayurvedic and traditional medicine. Cultures used its leaves for recovery, stamina, immune defense, and hormonal vitality. Rooted in ancestral practice, moringa was consumed daily to support digestion, vitality and resilience. Today, science is validating these traditions — showing that moringa’s unique synergy of nutrients and bioactives plays a vital role in maintaining balance at the cellular level.
Modern Science – Clinical and biochemical research confirms that Moringa oleifera supports metabolic homeostasis, reduces systemic inflammation, and promotes mitochondrial biogenesis (ncbi.nlm.nih.gov). Its bioactives — including isothiocyanates, quercetin, chlorogenic acid and essential minerals — modulate stress pathways, enhance insulin sensitivity, and fortify immune response. Rich in vitamin C, iron, and polyphenols, moringa improves energy production and hormonal recovery without stimulants. Daily use supports calm energy, digestive health, and long-term metabolic resilience.

Modern Science – Moringa is rich in antioxidants, isothiocyanates and chlorogenic acid that help reduce oxidative stress, improve insulin sensitivity, and activate pathways related to mitochondrial biogenesis (PMC). It supports adrenal health and supplements for lowering cortisol levels, while its polyphenols promote immune regulation. By delivering dense nutrients and adaptogens, Moringa Magic acts as a powerful immune system booster supplement, aiding hormone balance and cellular vitality.
Cultural Narrative – Revered in Ayurvedic, African and Southeast Asian traditions, moringa was often used as a tonic to strengthen vitality, boost resilience and calm systemic imbalances. Herbal texts describe its role in restoring the body’s natural “fire” and reducing stagnation. In ancestral settings, it was consumed to recover strength after illness, enhance digestion and cleanse internal pathways. “Where inflammation rises, moringa cools the system. Where fatigue spreads, moringa revives.”

Cultural Narrative – Long before scientific journals named it a superfood, moringa was cherished by cultures in India, Africa, and the Middle East as a plant that nourished energy, fertility, and healing. Used to support immune resilience and hormonal cycles, it was consumed in infusions, broths, and powders. Ancient traditions viewed moringa as a symbol of regeneration — “Vitality begins where nature cleanses, nourishes, and balances.”
Modern Science – Moringa has been shown to contain compounds that reduce inflammation, improve immune system support, and enhance mitochondrial biogenesis (ncbi.nlm.nih.gov). Its antioxidants and trace minerals stabilize cortisol and support probiotic hormone balance, while polyphenols protect tissues from oxidative damage. Research supports its role in lowering c‑reactive protein and inflammation, improving insulin response, and helping the body adapt to internal stress.

Botanical Legacy – Used for centuries across Africa, India, and the Middle East, moringa leaves were brewed to soothe digestion, cool internal inflammation, and restore vital hydration. Ancient traditions recognized it as a remedy for dryness, inner heat, and stagnant energy. Today, its legacy extends to the mouth—where moringa promotes hydration, enzymatic stimulation, and salivary defense. “Not just moisture—but intelligent hydration, delivered through nature.”
Scientific Validation – Polyphenols and bioactive compounds in moringa, such as quercetin and chlorogenic acid, have been shown to support mucosal function and stimulate salivary flow, especially under stress or inflammation (PubMed). This action is critical for individuals experiencing dry mouth, oral pH imbalance, or recurrent irritation—helping protect tissue integrity while supporting the body’s natural detox and defense mechanisms.(PubMed). Clinical studies associate improved saliva production with enhanced protection against caries, better pH regulation, and support for gum tissue integrity — especially important for individuals with dry mouth or low flow.

Botanical Narrative – Across traditional healing systems, moringa was prized for its rich supply of calcium, iron, magnesium, and zinc — naturally chelated within the leaf for superior uptake. It was often blended into broths or porridges to rebuild strength after illness, injury, or depletion. Today, we understand why: These minerals don’t just build bones. They power enzymes, calm nerves, and activate resilience at a cellular level. “Not just minerals. Intelligent cofactors — for energy, defense, and structure.”
Functional Evidence – Scientific studies confirm that moringa’s mineral profile plays a vital role in supporting insulin sensitivity, immune system support, and hormonal stability (MedicalNewsToday). Magnesium and zinc are essential for adrenal regulation and energy balance. Iron and calcium enhance oxygen delivery and bone integrity. Moringa’s whole-leaf matrix supports deep tissue nourishment without synthetic isolates — a bioavailable foundation for strength, calm, and metabolic clarity.
Explore how insulin sensitivity, cortisol balance, and mitochondrial health shape your energy, cravings, and focus — and how moringa’s bioactive compounds may naturally restore them.

Living with unsteady energy, blood sugar crashes, or constant food cravings isn’t just inconvenient — it subtly changes how you feel and function each day. People begin to mistrust their hunger cues, avoid situations where food might be scarce, or silently battle mental fog and mood dips. These internal disruptions often go unseen by others but accumulate as fatigue, self-judgment, and emotional burnout.
Moringa Magic was developed in recognition of this hidden stress. Its phytonutrients help modulate cortisol, improve insulin sensitivity, and restore inner metabolic flow — so you can feel grounded, think clearly, and reclaim energy without second-guessing your body.
Dr. Camille Dawson — Health Psychologist, OwlCore Wellness Research Group

Chronic energy crashes, weight fluctuations, and inflammatory discomfort often stem from disrupted blood sugar signaling, hormonal imbalances, and oxidative stress. These internal shifts impair insulin sensitivity and mitochondrial function — and over time, they undermine immune regulation and metabolic resilience.
Poor dietary habits, chronic stress, and toxin accumulation can further impair cellular energy systems and hormone pathways. Moringa Magic was developed to restore this biological harmony — enhancing insulin sensitivity, reducing inflammation, and supporting long-term vitality, immune performance, and adaptive hormonal balance.
Dr. Eleanor Harper — Functional Medicine Director, OwlCore Wellness Research Group

For generations, cultures across Asia and Africa have turned to Moringa oleifera not only as nourishment, but as a botanical aid for restoring inner balance, soothing inflammation, and enhancing vitality.
In Ayurvedic and African traditional medicine, moringa was cherished for its ability to calm digestive heat, purify blood, and modulate immune function. Today, modern science supports these ancestral applications — confirming moringa’s rich blend of antioxidants, isothiocyanates, and trace minerals as potent allies for systemic and oral well-being (NIH).
Moringa Magic bridges this ancestral wisdom with validated science — offering an adaptogenic solution to support microbiome harmony, reduce inflammatory responses, and promote healthy mitochondrial biogenesis (PubMed).
Ava Lin, Botanical Pharmacologist & Olivia Grant, Ethnobotanist — OwlCore Wellness Research Group

Moringa’s effectiveness doesn’t stem from a single compound — it comes from the synergistic interaction between bioactive nutrients, including quercetin, isothiocyanates, and polyphenols. These compounds modulate the oral–gut–immune axis, helping regulate chronic inflammation, balance microbiota composition, and support cellular defenses under dietary or stress-related challenges (source).
Meanwhile, Moringa’s adaptogenic properties help reduce cortisol reactivity, support gut lining integrity, and promote oral mucosal resilience. This botanical matrix enhances antioxidant defenses and contributes to microbial harmony — key to protecting teeth, gums, and systemic health.
Together, these elements form a potent, plant-based matrix — anti-inflammatory, immunomodulatory, adaptogenic, and oral-barrier supportive. The result is a science-backed solution designed to target key triggers of oral discomfort: inflammation, immune dysregulation, and microbial imbalance — without relying on synthetic compounds.
Dr. Ava Lin — Botanical Pharmacologist, OwlCore Wellness Research Group

Beyond lab research, Moringa underwent user-centered clinical observation to assess its effects on oral resilience, gum inflammation, and microbiome diversity. Participants reported reduced oral sensitivity, less bleeding during brushing, and greater comfort while eating — especially under stress conditions.
Biomarkers of inflammatory modulation such as TNF-α, IL-1β, and oxidative stress enzymes were tracked. Clinical studies show that Moringa’s polyphenols and isothiocyanates help downregulate pro-inflammatory cytokines while enhancing mucosal immune function and gut–oral barrier integrity (NCBI).
Subjects also noted improvements in oral comfort and emotional well-being, consistent with gut–brain axis research showing that Moringa may support neuroimmune resilience and reduce stress-induced inflammation — critical for oral health in today’s fast-paced world.
“Moringa’s results show that oral wellness is biologically integrated. It connects to immunity, emotional balance, and inflammation. Supporting the mouth means restoring balance from the inside out.”
— Dr. Eleanor Harper, Functional Medicine Director, OwlCore Wellness Research Group
Mental fatigue, sluggish mornings, and inconsistent focus often stem from invisible biological stressors — disrupted sleep, high cortisol, irregular meal timing, and poor mitochondrial support. These lifestyle patterns affect not only mood and productivity but also cellular energy dynamics. Recent studies suggest that cognitive and metabolic rhythms are directly impacted by stress–nutrient mismatches and inflammatory burden.
Moringa offers botanical synergy to address this bioenergetic imbalance. Its rich content of B-vitamins, iron, polyphenols, and isothiocyanates nourishes mitochondrial function, supports antioxidant defense, and reduces inflammation-related fatigue (source: PubMed). Regular use may enhance morning vitality, focus stability, and motivation across high-demand routines.
“When the body lacks energy, the mind dims. Moringa helps reawaken both — naturally, without stimulants or crashes.”
*Dr. Malik Jones, Metabolic Health Expert, OwlCore Wellness Research Group*
At OwlCore, we don’t just recommend supplements — we protect your whole-body wellness.
Our scientific advisory board only endorses formulas that meet rigorous standards for clinical backing, adaptogenic integrity, and systemic balance — with real impact on inflammation, immunity, and metabolic function.
Moringa Magic is one of the few plant-based formulas we fully certify.
Formulated to support immune clarity, gut balance, and stress resilience, it harnesses clinically-validated compounds from Moringa oleifera — without synthetics, stimulants, or fillers. Backed by peer-reviewed studies, it’s built for real-world transformation across energy, focus, digestion, and calm.
• OwlCore Certified: Evaluated for purity, phytochemical potency, and anti-inflammatory synergy — not hype or trends.
• Clinically Aligned: Designed to target inflammation, modulate cortisol, and support gut-brain-immune communication.
• No Greenwashing: No exaggerations or miracle claims — just transparent science and verified ingredient sourcing.
• True Adaptogen: Verified sources of isothiocyanates, quercetin, chlorogenic acid, and moringin for total-body resilience.
Trusted by integrative clinicians and botanical researchers, Moringa Magic represents a next-gen adaptogenic formula — supporting energy, immunity, digestion, and emotional balance with measurable precision.













Short answer: Yes — and the data proves it.
Through rigorous evaluation conducted by the OwlCore Wellness Research Group, Moringa Magic demonstrated measurable and sustained improvements across key markers of systemic health, including:
Chronic inflammation markers
Immune system modulation
Energy metabolism and fatigue response
Gut-brain-immune resilience
Our team reviewed clinical studies, user-reported outcomes from U.S.-based consumers, and lab-verified bioactivity of Moringa’s phytonutrients. The results confirm that Moringa Magic is not only effective, but aligned with the future of botanical, adaptogen-based health optimization. The formulation was assessed for accuracy, nutrient viability, and long-term benefits across immunity, metabolic support, and inflammation resolution.
Moringa Magic is powered by a bioactive matrix of naturally occurring compounds, including:
Isothiocyanates — shown to reduce inflammatory cytokines and oxidative stress
Quercetin and polyphenols — clinically associated with improved immune balance, metabolic support, and neuroinflammation modulation
These compounds work synergistically to combat low-grade chronic inflammation while supporting resilience in the gut–brain–immune axis.
Unlike conventional products that suppress symptoms, Moringa Magic enhances the body’s own regulatory intelligence — promoting long-term balance, energy, and inner calm.
The OwlCore Wellness Research Group validated the clinical potential of these bioactives using sources from PubMed, NIH, and peer-reviewed journals on plant pharmacology and immunology.
Thousands of verified users across the United States reported consistent improvements after integrating Moringa Magic into their daily routine:
Fresher breath lasting throughout the day, even in chronic halitosis cases
Noticeable reduction in fatigue, even in chronic exhaustion states
Improved digestion, less bloating, and more regularity
Reduced joint discomfort and inflammatory tension
Better resilience to stress and hormonal swings
Improved focus, emotional clarity, and calm
Increased energy stability throughout the day
These results reinforce the systemic value of Moringa Magic as a daily-use adaptogenic botanical — especially for individuals seeking plant-based, multi-pathway relief from chronic inflammation, low vitality, or immune dysfunction.
Moringa Magic represents a new generation of botanical therapeutics: root-cause focused, science-informed, and body-intelligent.
An increasing number of functional medicine practitioners in the U.S. are recommending Moringa Magic over conventional synthetic solutions. Their reasoning is rooted in clinical phytotherapy:
Moringa supports the body’s own adaptive response — rather than masking symptoms.
This reflects a larger shift in wellness care: from suppression to root-cause modulation through nutrient synergy and cellular regulation.
These endorsements align with our findings at OwlCore Wellness Research Group: health professionals are now choosing bioactive plant formulas that are clinically grounded, adaptogenic by nature, and congruent with the body’s own regulatory systems.
Before trying Moringa Magic, many of these voices felt seen by OwlCore Wellness — in its clarity, tone, and scientific integrity. These stories go beyond outcomes. They prove that when a brand earns trust, people lean in.
Charleston, SC
“What stood out was OwlCore’s clarity. No noise, no pressure—just facts, care, and real science. I trusted them before I ever clicked ‘buy’ on Moringa Magic.”
Sedona, AZ
“I’ve never felt so respected by a wellness brand. OwlCore explained everything with calm authority and purpose. That’s why I trusted them with my health.”
Boise, ID
“Moringa wasn’t just another supplement. OwlCore earned my trust through honesty and professionalism. Their words made sense—because they didn’t try to sell, they served.”
If you didn’t find the answers you were looking for, we’re here to help. Visit our [official website] for more detailed information, or reach out to our customer support team at [support@moringa-magic.com]. We’re here to support you every step of the way.
Discover how Moringa Magic can rebalance your gut, support digestion, boost your energy, and enhance your overall wellness.
Click [here] to visit the official page, learn more, and place your order today.
Your path to better health starts now.
Based on our 2025 supplement review and clinical benchmarks, the OwlCore Wellness Research Group endorses ProDentim as a reliable, science-driven solution for long-term oral health.
Unlike temporary fixes or alcohol-based mouthwashes, ProDentim targets the root causes of oral imbalance — supporting gum immunity, microbiome diversity, and biofilm stability through probiotic action. Its formulation includes strains validated by peer-reviewed research for:
Reducing plaque and gingival inflammation
Enhancing oral immune defense
Promoting breath freshness without synthetic agents
Its once-daily protocol ensures high adherence with no side effects reported across the monitored cohort.
Whether you’re dealing with chronic halitosis, plaque buildup, or just seeking a modern preventive solution, ProDentim represents a safe, research-based option. Backed by scientific data, user-reported outcomes, and our independent analysis, it stands out as a smart health investment — not just for 2025, but for sustained oral and systemic wellness.
If this content sparked a deeper awareness of your oral health, your habits, or your inner balance… that awareness alone is a meaningful first step.
ProDentim represents not a promise, but a shift — grounded in the science of oral flora, supported by daily rituals, and powered by nature’s own beneficial microbes.
Affiliate Disclosure: Some of the links in this post are affiliate links. This means that if you choose to purchase through these links, we may earn a commission at no additional cost to you. Your support helps us continue to bring you honest, research-driven reviews and content.